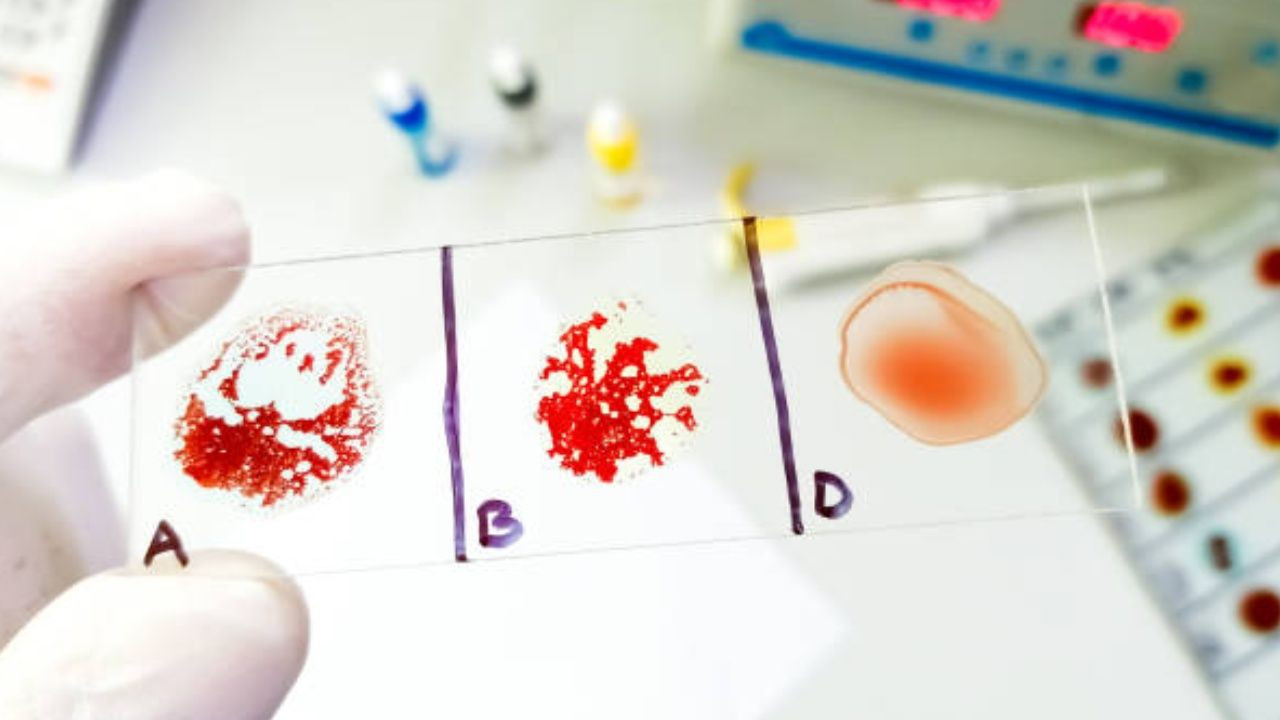
En zeki insanların çıktığı kan grubu; Türkiye’de çoğunluk bu kan grubunda yer alıyor. - Sayfa 6

Kan grupları insan sağlığı açısından büyük önem taşır. A, B, AB ve 0 olmak üzere dört ana gruba ayrılan bu sistem, Rh pozitif ve Rh negatif faktörleriyle çeşitlilik gösterir.
En zeki insanların çıktığı kan grubu; Türkiye’de çoğunluk bu kan grubunda yer alıyor.
Yapılan laboratuvar araştırmalarında en zeki kan grubunun hangisi olduğu belirlendi. Ülkemizde de en zeki kan grubu çoğunlukta.


Kan grubu, bağış ve nakil süreçlerinde hayat kurtarıcı rol oynar. Acil durumlarda doğru gruptan kan temini, hastaların tedavisinde kritik değer taşır.

Toplumda en yaygın grup 0 Rh pozitif olarak bilinirken, AB Rh negatif en az rastlanan gruplardan biridir. Kan bağışı kampanyaları, ihtiyaç sahiplerine destek olur.

EN ZEKİ KAN GRUBU A
labmedya.com sitesinde derlenen bilgiye göre en zeki kan grubu A olarak biliniyor. Kan grupları ile ilgili yapılan araştırmada; A grubunun alt grubu olan A 2’de IQ’nun daha yüksek olduğu, genele bakıldığında da A grubu kana sahip kişilerin IQ’ları içinde aynı şeyin olduğu sonucuna varılıyor.

İngiltere’de yapılan bir araştırmada da, kan gruplarının sosyo -ekonomik açıdan nasıl bir dağılım gösterdikleri araştırılıyor ve A grubunun sosyo ekonomik seviyesinin daha yüksek olduğu görülüyor.
TÜRKİYE’DE KAN GRUPLARININ DAĞILIMI
Bu sonuç IQ’su yüksek ve aktif insanların çok daha başarılı olduklarını ve daha iyi yerlere geldiklerini gösteriyor.

Türkiye’de ise en.wikipedia.org/wiki/Blood_type_distribution_by_country linkinde derlenen bilgiye göre kan gruplarının nüfusa dağılımı şu şekilde:
0+ %29,4
A+ %38,3
B+ %13,2
AB+ %6,4
0- %4,4
A- %5,5
B- %2,1
AB- %0,7
Kaynak: labmedya.com * vikipedia.com
Derleme: superhaber.com